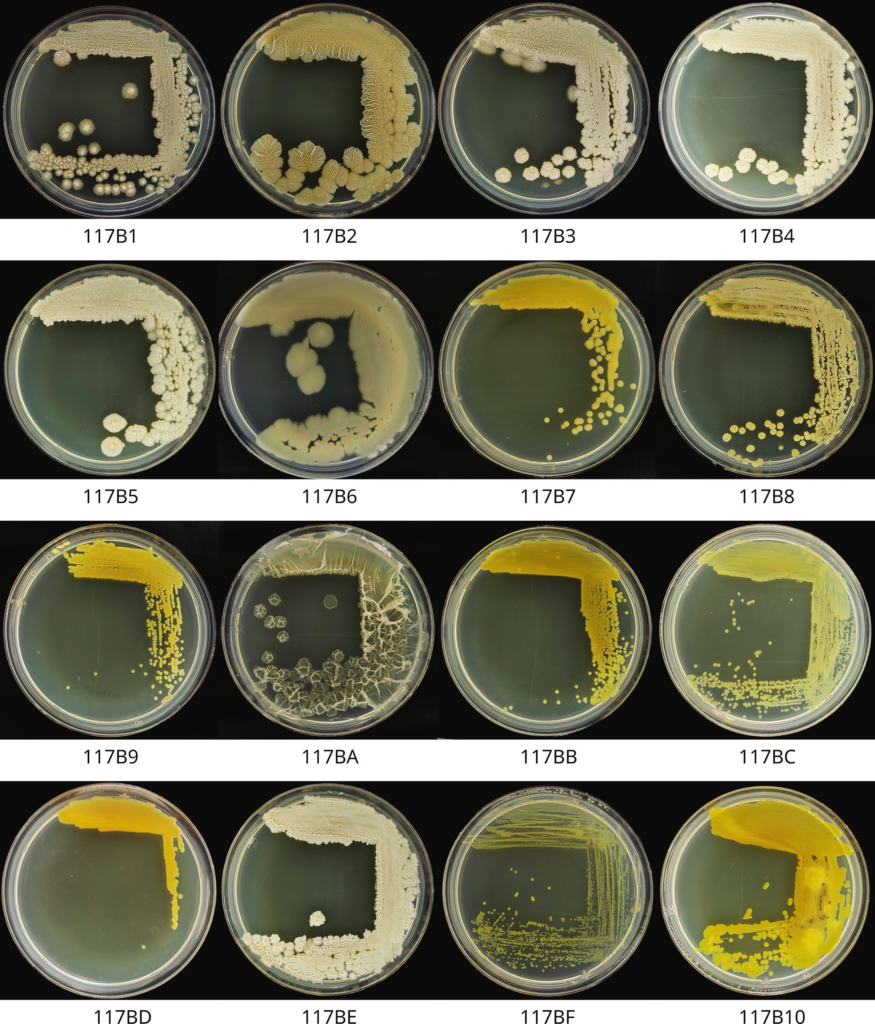

Современное сельское хозяйство сталкивается с проблемами, которые усиливают необходимость поиска экологически безопасных альтернатив химическим препаратам. Из ризосферы Orostachys spinosa (L.) выделены, идентифицированы и изучены 16 бактериальных изолятов, которые относятся к родам Pseudomonas, Bacillus, Curtobacterium. Штаммы могут быть использованы в сельском хозяйстве в качестве биоконтроля (р. Bacillus) или фитостимуляторов (р. Pseudomonas).
[https://doi.org/10.26907/2542-064X.2026.1.139-160
Суханов, А. Ю., Фролов, М., Некрасов, И. В., Ложкарев, Т. А., Валидов, Ш. З. (2026). Выделение, идентификация и оценка полезных свойств микроорганизмов из Orostachys spinosa (L.) лесной зоны Прибайкалья. Ученые записки Казанского университета. Серия Естественные науки. 2026, 168(1), 139-160].
Интенсификация возделывания культур приводит к истощению почвенного плодородия: постоянное использование азотных, фосфорных и калийных удобрений снижает биологическую активность микробиома, ухудшает структуру почвы и уменьшает ее способность удерживать влагу. Одновременно избыточное применение пестицидов вызывает накопление токсичных остатков, ухудшает качество воды и создает резистентность у патогенных организмов. В этих условиях биологический контроль, основанный на местных микробиологических симбионтах, представляет собой перспективный путь к устойчивому управлению агроэкосистемами.
Ризосфера растений, в частности суккулентного Orostachys spinosa (L.), является богатым источником бактерий, способных фиксировать атмосферный азот, мобилизовать нерастворимые фосфаты, синтезировать фитогормоны, например ауксины, и подавлять рост фитопатогенов. Выделение и детальная характеристика таких штаммов позволяет разработать биопрепараты, которые одновременно снижают потребность в минеральных удобрениях и уменьшают нагрузку химических фунгицидов.
Проведенное исследование по выделению, идентификации и анализу штаммов позволило обнаружить 16 бактериальных изолятов в ризосфере O. spinosa (L.), большинство из которых относятся к родам Pseudomonas и Bacillus, а отдельные представители – к роду Curtobacterium (рис. 1).
Рис. 1. Морфология колоний полученных бактериальных изолятов
При оценке антагонистической активности в отношении патогенных микромицетов рода Fusarium, способности продуцировать ауксины, а также выделять внеклеточные ферменты (целлюлазы и фитазы) отобраны перспективные штаммы – Bacillus sp. 117BA и 117BE, а также Pseudomonas sp. 117BB и 117BD (рис. 2).

Рис. 2. Антагонистическая активность бактериальных изолятов против
Fusarium sp. Fo2, Fusarium proliferatum Fo4, Fo8
Штаммы рода Bacillus показывают хорошую антагонистическую и ферментативную активность, а также способность усваивать атмосферный азот. Продукция ауксинов у них находится на среднем уровне среди всех штаммов. Для штаммов рода Pseudomonas антагонистическая активность не зафиксирована, но обнаружена фитазная активность и способность усваивать атмосферный азот. Уровень продукции ауксина аналогичен штаммам группы Bacillus (рис. 3).

Рис. 3. Средняя концентрация ауксина в среде после инкубации штаммов бактерий:
С – отрицательный контроль
Выделенные штаммы могут быть использованы в сельском хозяйстве в качестве биоконтроля (представители рода Bacillus) или фитостимуляторов (р. Pseudomonas). Их внедрение позволит сократить зависимость от химических удобрений и пестицидов, повысить урожайность сельскохозяйственных культур и укрепить их устойчивость к стрессам.




